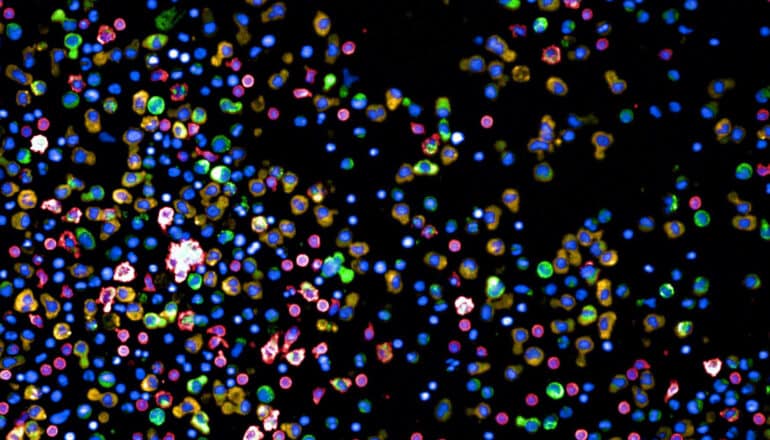

Researchers set out to improve multiple myeloma treatment outcomes by testing hundreds of existing therapeutics outside the body to predict their effectiveness.
Multiple myeloma is a rare blood cancer caused by the uncontrolled multiplication of abnormal plasma cells. These plasma cells are a special type of white blood cells that play an important role in the immune system by producing essential antibodies in the bone marrow and lymph nodes.
Despite an increasing number of approved drugs and treatment approaches such as immunotherapy becoming available, the disease is still not curable. The average life expectancy of patients after diagnosis is only five years.
One of the main challenges is the cancer’s tendency to return even after treatment. This is because treatment makes the cancer cells more resistant to the drugs used, until eventually, after several rounds of treatment, no effective options remain.
To address this issue, the researchers have adapted their screening platform to look for ways out of this problem, and thereby offering new hope for more successful treatment outcomes.
Hundreds of treatment combinations
For the study, the researchers are using a high-throughput screening method called pharmacoscopy, developed by Berend Snijder, professor at ETH Zurich, to test the effectiveness of various treatments on the patient’s cancer cells.
This state-of-the-art method allows for several hundred different treatment combinations to be tested simultaneously outside the body. By analyzing the reactions of the cells to each treatment, they can determine which method holds the most promise for each patient.
To do this, the researchers place the cells from the biopsies in special plates with 384 small wells, each containing a different combination of potential treatment substances. After 24 hours, the cells are stained using different antibodies, and their reactions are evaluated using images generated by automated microscopy. The researchers then use a deep-learning algorithm to identify and classify the cell types. The process is largely automated, allowing for efficient and accurate analysis of the results.
The researchers used pharmacoscopy to closely examine 138 bone marrow biopsies from 89 myeloma patients with different stages of multiple myeloma, including newly diagnosed and untreated, as well as patients that underwent multiple treatment rounds.
The goal was to observe the behavior of cancer cells in response to various approved drugs and drug combinations in each biopsy. Based on the cells’ appearance, the researchers could determine the best treatment option for each patient.
Although the Snijder lab had previously used pharmacoscopy in similar studies on other types of blood cancer, such as lymphomas and leukemias, the platform had to be adapted for this myeloma study.
Promising advance for multiple myeloma
The groundbreaking work offers hope for more effective treatments for multiple myeloma. Using pharmacoscopy to test hundreds of treatments, allowed the researchers to identify new, more effective treatment options for each patient.
This new personalized medicine approach is transferable to the clinic and can thus help doctors find the best option for their patients at an early stage. “First, however, we will have to validate the method further in clinical trials,” Snijder says.
Now, the Snijder lab wants to develop the platform further to expand its use to solid tumors. Unlike blood cancers, solid tumors must first be dissociated to a certain degree before they can be tested in the 384-well plate format. They are currently adapting the screening platform for brain tumors, among others.
The study appears in Nature Cancer.
Source: ETH Zurich
The post Screening may lead to custom treatments for rare blood cancer appeared first on Futurity.
from Futurity https://ift.tt/CastEJN
No comments:
Post a Comment